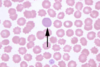

Broca’s area is which Brodmann areas? [2]
44 & 45
Wernicke’s area is which Brodmann area? [1]
22
Frontal eye field is which Brodmann area? [1]
8
Primary somatosenory cortex is which Brodmann’s areas? [3]
1,2,3
Primary motor cortex is which Brodmann area? [1]
4
Primary auditory cortex is which Brodmann area? [1]
41
Locus coeruleus causes the release of which hormone? [1]
Noradrenaline
Shingles is most likely to activate in which branch of the trigeminal nerve? [1]
V1; opthalmic nerve
Shaken baby syndrome has a triad of which three signs? [3]
Retinal haem.; encephalopathy; subdural haem.
Tx for status epilepticus? [1]
Lorezapam
A
B
C
D
E

C: thalamus
How would bilateral pleural effusion present on auscultation
a. Fine crackles
b. Course crackles
c. Wheeze
d. Increased breath sounds
e. Absent breath sounds
e. Absent breath sounds
What is the Thomas’ test assessing
a. Fixed flexion deformity
b. Fixed extension deformity
c. Fixed rotation deformity
d. Tenderness over the acetabulofemoral joint
e. Sciatic nerve compression
a. Fixed flexion deformity
What would be the results of the Weber and Rinne test in a sensorineural loss?
a. Weber’s test: Both ears equal, Rinne’s test: Bone louder than air
b. Weber’s test: Louder in affected ear, Rinne’s test: Bone louder than air
c. Weber’s test: Louder in unaffected ear, Rinne’s test: Air louder than bone
d. Weber’s test: Both ears equal, Rinne’s test: Air louder than bone
e. Weber’s test: Louder in affected ear, Rinne’s test: Bone louder than air
c. Weber’s test: Louder in unaffected ear, Rinne’s test: Air louder than bone
A medical student is testing pupillary reflexes, and notices that when they shine a light onto the left eye, the left eye constricts but the right eye stays the same. What nerve is most likely damaged?
a. Left optic nerve
b. Right optic nerve
c. Left oculomotor nerve
d. Right oculomotor nerve
e. Both optic and oculomotor nerves
d. Right oculomotor nerve
A patient is undergoing a neurological exam. When testing power, they are able to move when there is no resistance. What grade in the MRC power grading scale does this come under?
3
A patient presents with colicky pain, and upon examination is shown to have a positive Murphy’s test. He is not jaundiced. What does he most likely have, and where would the pathology be located? (vSAQ)
Gallstones, in the cystic duct / cholecystitis
Chronic myeloid leukaemia occurs from a translocation which two chromosomes? [2]
9 & 22
Colorectal cancer increases the liklihood of secreting with molecule? [1]
Serum carcinoembryonic antigen (CEA)
Substantia nigra
Arcuate nucleus
Ventral tegmental area
Caudal raphe nuclei
Dorsal raphe nuclei

Answer: Ventral tegmental area
The mesolimbic pathway is a dopaminergic pathway connecting the ventral tegmental area to the ventral striatum (the nucleus accumbens and the olfactory tubercle), the amygdala and the hippocampus.
Damage to the fornix causes what type of memory loss? [1]
Anterograde amenesia
Narrowing of the cerebral aqueduct leads to hydrocephalus. How can this present in patients? [1]
Bilateral vertical gaze palsy
The midbrain is supplied by which artery? [1]
PCA
The midbrain is supplied by which artery? [1]
PCA